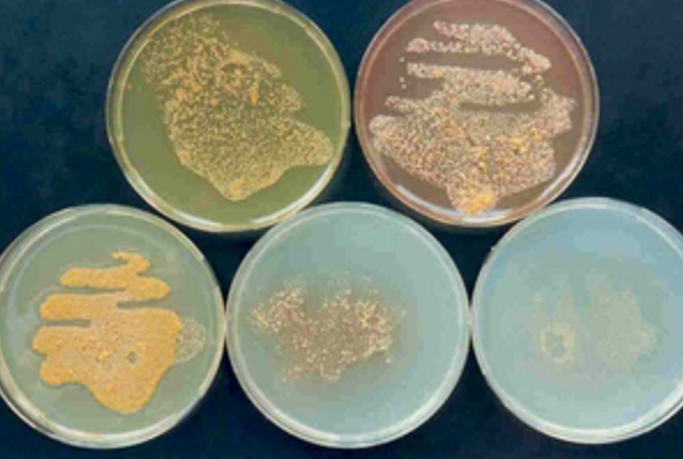
DSMZ微生物菌种

品牌列表
Brand list
DSMZ是德国的国家菌种保藏中心,成立于1969年,该保藏中心一直致力于细菌、真菌、质粒、抗菌素、人体和动物细胞、植物病毒等的分类、鉴定和保藏工作。DSMZ保藏中心接收的所有生物材料均会接受中央服务部门的质量控制和生理及分子特性检测。此外,DSMZ还提供有关生物材料的详尽文档和详细诊断信息。
DSMZ目前收藏超过70,000种产品,包括约31,000种不同的细菌和6,500种真菌菌株,830种人和动物细胞系,1,500种植物病毒和抗血清,2,000种质粒和噬菌体以及13,000种不同类型的细菌基因组DNA。
微生物:DSMZ 微生物开放收藏包含超过 32,200 种生物资源,约占已知微生物多样性的 80%。
DSMZ微生物菌种
人和动物细胞系:DSMZ 细胞系目前包含从众多组织以及许多杂交瘤中分离的灵长类动物、啮齿动物、两栖动物、鱼类和昆虫来源的 950 多种不同的永生化细胞培养物。

DSMZ人和动物细胞系
植物病毒和抗血清:提供不断增长的植物病毒分离物谱和高质量血清学试剂,以及用于农业和园艺作物中最重要的植物病毒常规检测的相应阳性对照。

DSMZ植物病毒和抗血清